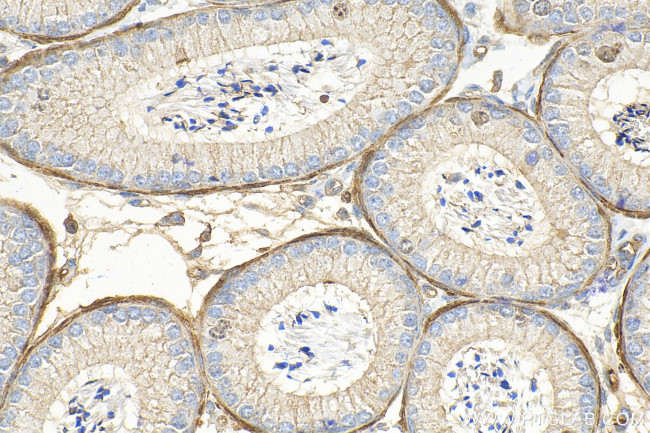
SLC26A3 Antibody in Immunohistochemistry (Paraffin) (IHC (P))

Search
Proteintech
SLC26A3 Polyclonal Antibody
{{$productOrderCtrl.translations['antibody.pdp.commerceCard.promotion.promotions']}}
{{$productOrderCtrl.translations['antibody.pdp.commerceCard.promotion.viewpromo']}}
{{$productOrderCtrl.translations['antibody.pdp.commerceCard.promotion.promocode']}}: {{promo.promoCode}} {{promo.promoTitle}} {{promo.promoDescription}}. {{$productOrderCtrl.translations['antibody.pdp.commerceCard.promotion.learnmore']}}
产品信息
13165-1-AP
种属反应
宿主/亚型
分类
类型
抗原
偶联物
形式
浓度
规格
纯化类型
保存液
内含物
保存条件
运输条件
产品详细信息
Sequence of this protein is as follows: LTIVFRTQFP KCSTLANIGR TNIYKNKKDY YDMYEPEGVK IFRCPSPIYF ANIGFFRRKL IDAVGFSPLR ILRKRNKALR KIRKLQKQGL LQVTPKGFIC TVDTIKDSDE ELDNNQIEVL DQPINTTDLP FHIDWNDDLP LNIEVPKISL HSLILDFSAV SFLDVSSVRG LKSILQEFIR IKVDVYIVGT DDDFIEKLNR YEFFDGEVKS SIFFLTIHDA VLHILMKKDY STSKFNPSQE KDGKIDFTIN TNGGLRNRVY EVPVETKF
靶标信息
SLC26A3 is a chloride/bicarbonate exchanger that is involved in absorption inside the colon. SLC26A3 helps mediate electrolyte and fluid absorption. The protein encoded by the SLC26A3 gene is a transmembrane glycoprotein that functions as a sulfate transporter, and it is localized to the mucosa. The chloride ions transported by SLC26A3 cross the cell membrane in exchange for biocarbonate ions. SLC26A3 is localized in the mucosa of the lower intestinal tract, specifically the apical membrane of the columnar epithelium and in some goblet cells. Diseases associated with SLC26A3 protein dysfunction include congenital chloride diarrhea and congenital secretory chloride diarrhea 1.
仅用于科研。不用于诊断过程。未经明确授权不得转售。
篇参考文献 (0)
生物信息学
蛋白别名: Chloride anion exchanger; Down-regulated in adenoma; down-regulated in adenoma protein; Nuclear localization signal at AA 569-573, 576-580, 579-583; acidic transcr. activ. domain 620-640,; homeobox motif 653-676; Protein DRA; solute carrier family 26 (anion exchanger), member 3; Solute carrier family 26 member 3; unnamed protein product
基因别名: 9030623B18Rik; 9130013M11Rik; AV376035; CLD; DRA; SLC26A3
UniProt ID: (Human) P40879, (Mouse) Q9WVC8
Entrez Gene ID: (Human) 1811, (Mouse) 13487